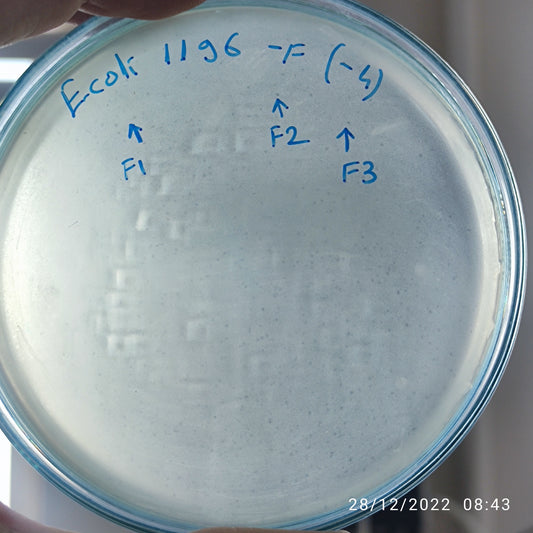
Escherichia coli bacteriophage 101196F
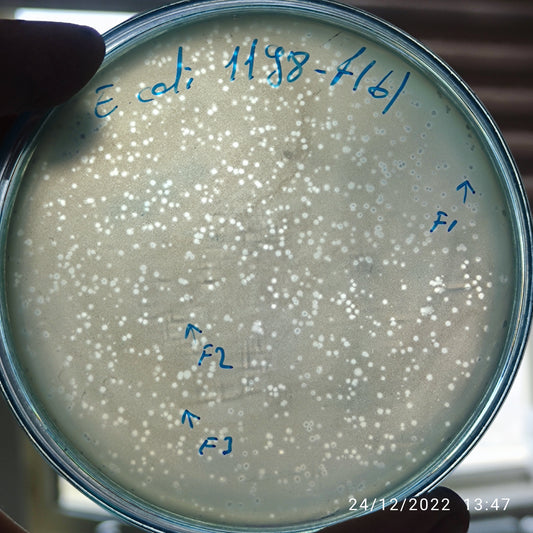
Escherichia coli bacteriophage 101198F
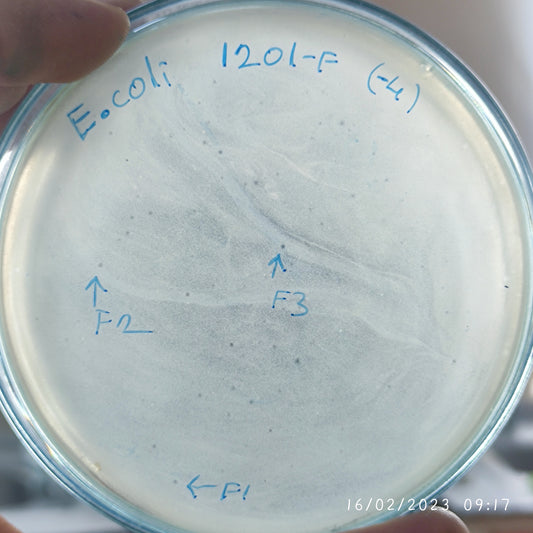
Escherichia coli bacteriophage 101201F
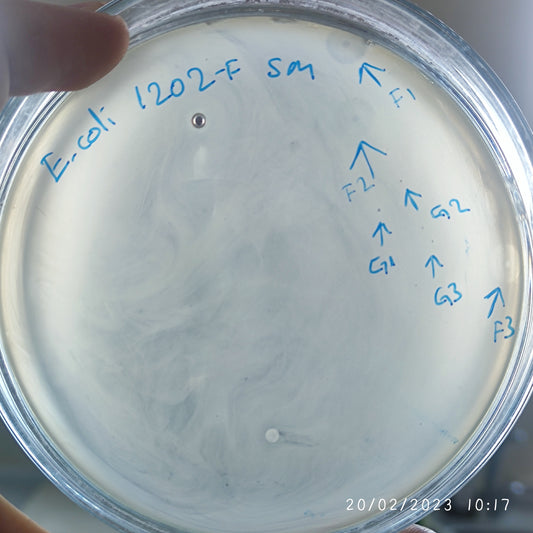
Escherichia coli bacteriophage 101202F
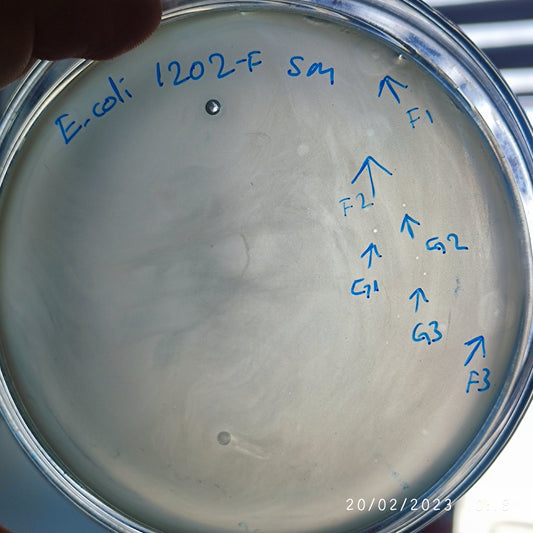
Escherichia coli bacteriophage 101202G
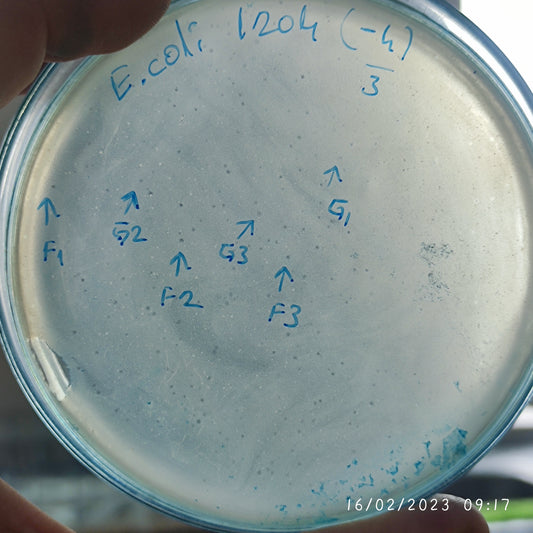
Escherichia coli bacteriophage 101204G
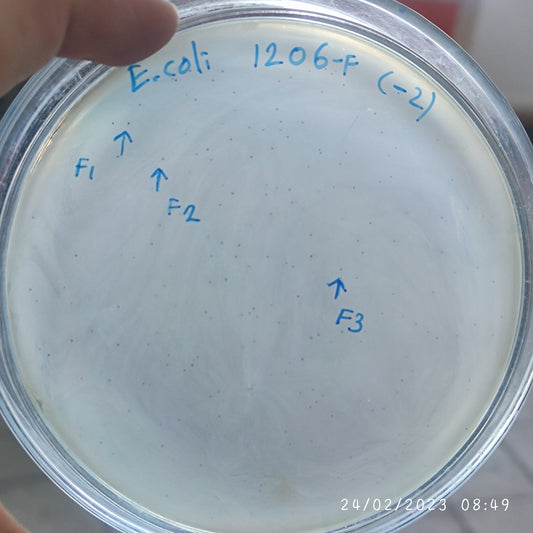
Escherichia coli bacteriophage 101206F
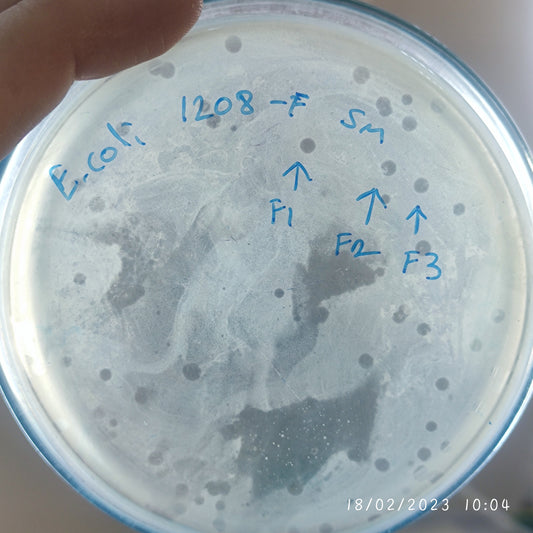
Escherichia coli bacteriophage 101208F
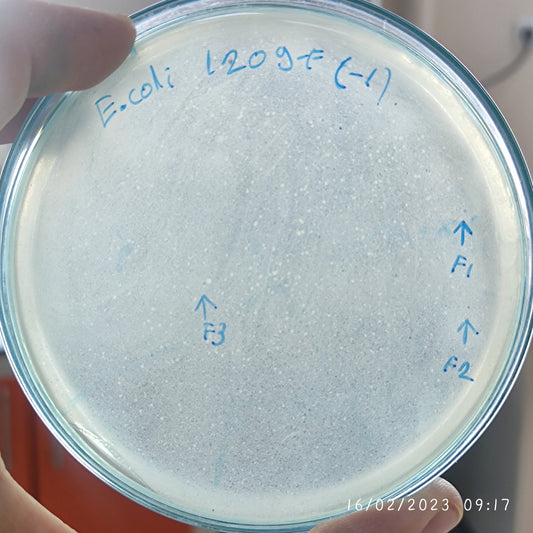
Escherichia coli bacteriophage 101209F
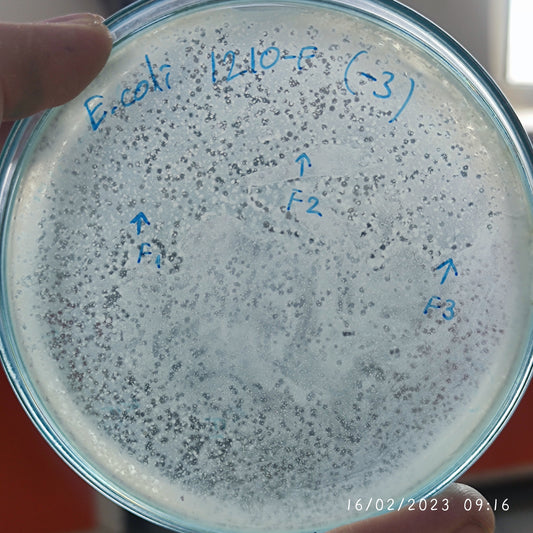
Escherichia coli bacteriophage 101210F
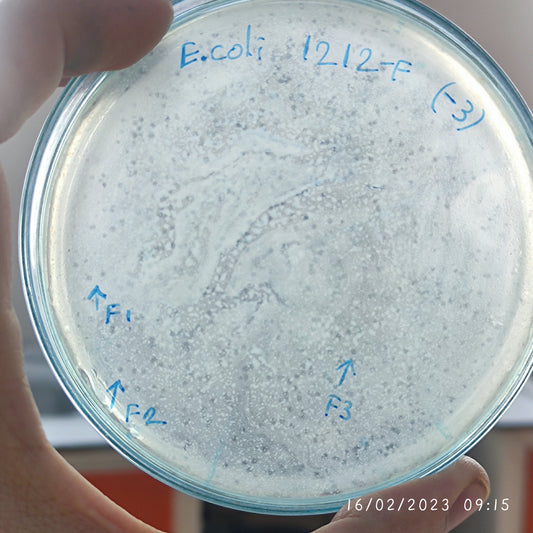
Escherichia coli bacteriophage 101212F

-
Escherichia coli bacteriophage 101194G
Regular price $500.00 USDRegular priceUnit price per -
Escherichia coli bacteriophage 101194H
Regular price $500.00 USDRegular priceUnit price per$500.00 USDSale price $500.00 USD -
Escherichia coli bacteriophage 101196F
Regular price $500.00 USDRegular priceUnit price per -
Escherichia coli bacteriophage 101198F
Regular price $500.00 USDRegular priceUnit price per -
Escherichia coli bacteriophage 101200F
Regular price $500.00 USDRegular priceUnit price per -
Escherichia coli bacteriophage 101201F
Regular price $500.00 USDRegular priceUnit price per -
Escherichia coli bacteriophage 101202F
Regular price $500.00 USDRegular priceUnit price per -
Escherichia coli bacteriophage 101202G
Regular price $500.00 USDRegular priceUnit price per -
Escherichia coli bacteriophage 101204F
Regular price $500.00 USDRegular priceUnit price per -
Escherichia coli bacteriophage 101204G
Regular price $500.00 USDRegular priceUnit price per -
Escherichia coli bacteriophage 101205F
Regular price $500.00 USDRegular priceUnit price per -
Escherichia coli bacteriophage 101206F
Regular price $500.00 USDRegular priceUnit price per -
Escherichia coli bacteriophage 101208F
Regular price $500.00 USDRegular priceUnit price per -
Escherichia coli bacteriophage 101209F
Regular price $500.00 USDRegular priceUnit price per -
Escherichia coli bacteriophage 101210F
Regular price $500.00 USDRegular priceUnit price per -
Escherichia coli bacteriophage 101212F
Regular price $500.00 USDRegular priceUnit price per